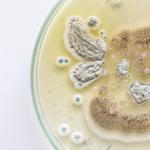
Test my Home Caldwell - photo 5

Test my Home Caldwell
About Business
The importance of a healthy home cannot be overstated. In today's society, people spend an average of 500 hours at their homes per year, yet an inspector from the government has energy-efficiency tested less than 10%. Healthy homes have the right combination of heating, cooling, and ventilation systems to keep their inhabitants healthy. However, there is no government regulation on how well these HVACs must be installed, so it's crucial for you as a buyer or owner/renter to ensure they are working correctly before moving into your property. Healthy Home Assessment is critical because it helps you understand your specific situation and what steps are needed to maintain a healthy home environment.
Other Businesses

Environmental Testing
Sullivan Environmental

Environmental Testing
MSE Environmental

Environmental Testing
Benchmark Environmental Engineering

Environmental Testing
Green Canada Energy Advisors Inc.

Environmental Testing
For Green Heat

Environmental Abatement
Radon Doctors

Damage Restoration
Florida Mold Testers LLC

Environmental Abatement